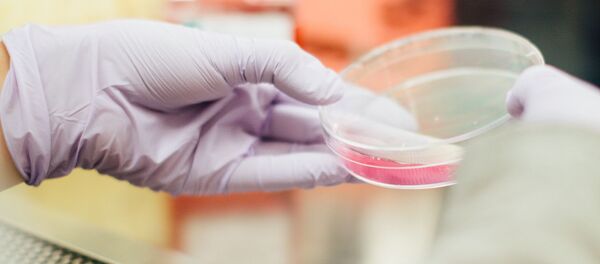
Лаборатория Лаборатория - Sputnik Абхазия

СУХУМ, 22 авг - Sputnik. Сразу в нескольких экспериментах пожилые добровольцы не могли точно определить длительность интервала между двумя сигналами. Как правило, им казалось, что он короче, чем на самом деле. Одни исследователи объясняют это замедлением работы мозга, другие — предыдущим опытом, который искажает восприятие, пишет Альфия Еникеева для РИА Новости.
Не думай о секундах свысока
В течение 35 лет американский биомедик Роберт Сотерн каждое утро мерил себе температуру, артериальное давление, пульс и оценивал, как долго для него длится одна минута. Все результаты аккуратно записывал. Они затем легли в основу исследования, которое показало: с возрастом время ускоряется — точнее, его восприятие.
Если в начале эксперимента Сотерн правильно определял длительность минуты, то к 60 годам она для него увеличилась на несколько секунд. Похожим образом дело обстояло в группах добровольцев 60-80 лет, которых попросили оценить временной интервал в три минуты. Они ошибались секунд на 40. Молодые — от 19 до 24 лет — были на порядок точнее.
Мозг замедляется, время ускоряется
Это можно объяснить скоростью работы мозга, считают исследователи Университета Дьюка (США). Чем старше человек, тем медленнее мозг обрабатывает внешние образы и начинает как бы отставать от физического времени. Субъективно кажется, что оно ускорилось.
Кроме того, восприятие часов, минут и секунд тесно связано с быстрыми согласованными движениями глаз в одном направлении — саккадами, развитыми только у приматов и играющими важную роль в освоении окружающего мира. Между саккадами мозг обрабатывает визуальную информацию. И у детей это происходит быстрее, поэтому их субъективное время течет медленнее.
Впрочем, взрослые тоже вполне могут немного притормозить. Для этого надо высыпаться и отдыхать, ведь на скорость процессов в мозге влияет не только возраст, но и хроническая усталость, отмечают авторы работы.
Трудности восприятия
По мнению немецких ученых, ощущение времени во многом зависит от воспринимаемой визуальной информации, точнее от ее сложности. В их эксперименте добровольцам поочередно показывали простые картинки и несимметричные изображения с большим количеством мелких деталей. В итоге участники утверждали, что на сложные рисунки они смотрели меньше, чем на более простые. Это, конечно, было не так.
Однако важнее всего слух, считают британские нейрофизиологи. Они продемонстрировали, что при повреждении участков мозга, отвечающих за слух, человек не может правильно оценить ни длительность звука, ни время просмотра картинки. При нарушениях в зонах мозга, связанных со зрением, ошибки случаются только при попытках определить длительность визуального стимула. Значит, предположили исследователи, время распознается в участках головной коры, отвечающих за слух, а визуальные сигналы автоматически сопоставляются со звуковыми.
И именно с этим стареющему мозгу сложнее справиться, полагают канадские ученые. Пожилые люди могут в разговоре потерять нить беседы, испытывают трудности при вождении автомобиля. И время для них идет быстрее, чем в юности.
К таким выводам специалисты пришли, наблюдая за реакцией добровольцев на два типа раздражителей — белые круги, появляющиеся на экране монитора, и звуковые сигналы. Внешние стимулы выводили то вместе, то по отдельности — сначала геометрические фигуры, а потом звуки. Добровольцы должны были в течение трех секунд решить, происходили оба этих события одновременно или нет, и нажать на одну из двух кнопок на специальном пульте.
Выяснилось, что количество ошибок зависит от возраста. Судя по всему, мозг 50-60-летних хуже справлялся со "склейкой" данных. Это тоже объясняет, почему для пожилых людей время бежит быстрее.
Кроме того, согласно последним данным, c годами меняется активность гиппокампа, из-за чего люди не способны правильно определять границы событий. То есть пожилым сложнее разделить непрерывный поток информации на отдельные части и отсеять ненужное. Кстати, от этого страдает и память: чтобы не забыть конкретные события, нужно четко проводить границы между ними.
Опыт решает все
По мнению британских исследователей, следует учитывать также пережитый опыт. Если несколько раз подряд повторять один и тот же сигнал, человеку кажется, что время его демонстрации сократилось, хотя на самом деле это не так. Поскольку большинство людей изо дня в день сталкиваются с одними и теми же событиями, нет ничего удивительного, что время с возрастом ускоряется, отмечают ученые.
К похожим выводам пришли и нейрофизиологи из Массачусетского технологического института (США). Правда, они экспериментировали не на людях, а на лабораторных мышах. Грызунов обучили определять интервал между двумя вспышками света, а затем спустя такой же промежуток времени выполнять специальную команду.
Привыкнув к короткому интервалу — от 400 до 700 миллисекунд (а время между сигналами на самом деле составляло восемьсот миллисекунд), животное выполняло команду раньше. Если же мышь приучили к интервалу от 900 до 1200 миллисекунд, то она реагировала немного позже.
То есть предыдущий опыт влиял на принятие решения и восприятие времени. Более того, анализ 1400 мышиных нейронов в лобной доле головного мозга — считается, что как раз эта зона отвечает за чувство времени, — показал: активность нервных клеток у животных была разной. Из чего следует вывод: мозг способен встраивать предыдущий опыт в структуру синаптических связей.
Впоследствии это подтвердили на компьютерной модели. Как и в настоящем мозге, предыдущий опыт влиял на восприятие времени. Когда же ученые удаляли эти представления, время не искажалось.
Однако мозг — не компьютерная модель и удалить из него пережитое практически невозможно. Правда, если постоянно тянуться к чему-то новому и добавить в жизнь больше разнообразия, ход времени вполне можно замедлить, отмечают исследователи из Дартмутского колледжа (США). В их экспериментах людям показывали хорошо знакомые им картинки и те, которые они никогда раньше не видели. Большинство испытуемых считало, что незнакомые рисунки были на экране дольше других.